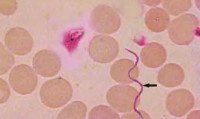

Другие названия и синонимы
Recurrent typhus.
МКБ-10 коды
|
|
Описание
Возвратный тиф (лат. typhus recurrens) - собирательное название, объединяющее эпидемический (переносчик возбудителя - вошь) и эндемический (переносчик возбудителя - клещ) спирохетозы, протекающие с чередованием приступов лихорадки и периодов нормальной температуры тела.
Клиническая картина
Первый приступ начинается внезапно: кратковременный озноб сменяется жаром и головной болью; появляются боли в суставах и мышцах (главным образом икроножных), тошнота и рвота. Температура быстро поднимается, пульс частый, кожа сухая. В патологический процесс вовлекается нервная система, часто возникает делирий. На высоте приступа появляются различной формы высыпания на коже, увеличиваются селезенка и печень, иногда развивается желтуха. Во время лихорадки могут отмечаться признаки поражения сердца, а также бронхит или пневмония. Приступ продолжается от двух до шести дней, после чего температура падает до нормальной или субфебрильной и самочувствие больного быстро улучшается. Однако через 4-8 суток развивается следующий приступ с теми же симптомами. Случаи заболевания без повторных приступов редки.
Для вшиного возвратного тифа характерны один-два повторных приступа, которые заканчиваются полным выздоровлением и временным иммунитетом. Для клещевого возвратного тифа характерны четыре и более приступов лихорадки, они короче и легче по клиническим проявлениям, хотя второй приступ может быть тяжелее, чем первый.
Ассоциированные симптомы: Высокая температура тела. Недомогание. Озноб. Олигурия. Отсутствие аппетита. Понос (диарея). Рвота. Тошнота.
Для вшиного возвратного тифа характерны один-два повторных приступа, которые заканчиваются полным выздоровлением и временным иммунитетом. Для клещевого возвратного тифа характерны четыре и более приступов лихорадки, они короче и легче по клиническим проявлениям, хотя второй приступ может быть тяжелее, чем первый.
Ассоциированные симптомы: Высокая температура тела. Недомогание. Озноб. Олигурия. Отсутствие аппетита. Понос (диарея). Рвота. Тошнота.
Причины
Возбудители возвратного тифа относятся к спирохетам рода вorrelia, в частности, один из наиболее распространённых возбудителей тифа эпидемического - бореллия Обермейера вorellia Obermeieri, открытая в 1868 году Отто Обермейером.
Клещевой возвратный тиф - зоонозное трансмиссивное заболевание. Возбудителями являются многие виды боррелий: В. duttonii, В. persica, В. hispanica, В. latyschewii, В. caucasica, распространенные в определенных географических зонах. Эти боррелии сходны с возбудителем эпидемического возвратного тифа по морфологии, резистентности к действию факторов окружающей среды, биологическим свойствам.
Переносчики. Клещевой возвратный тиф является облигатно-трансмиссивным заболеванием. Переносится клещами семейства Argasidae, такими как Ornitodorus papillares (поселковый клещ), Argas persicus (персидский клещ). Клещи являются резервуарными хозяевами спирохет. Резервуаром боррелий различных видов в природных очагах являются также разные виды грызунов. Зараженность клещей сохраняется в течение всей их жизни (около 10 лет). Имеет место и трансовариальная передача возбудителей, которые проникают в яйцевод и яйцеклетки членистоногих. В природных очагах происходит постоянная циркуляция возбудителя от грызунов к клещам и обратно. Животные и паразитирующие на них клещи обычно накапливаются в норах, пещерах, но находят для себя обитание и в различных хозяйственных строениях в населенных пунктах.
Человек заражается при укусах клеща. На месте инокуляции возбудителя образуется папула (первичный аффект).
Население эндемичных по клещевому возвратному тифу районов приобретает определенную степень невосприимчивости к циркулирующим возбудителям - в сыворотке крови у них обнаруживаются антитела к боррелиям, распространенным в этом регионе. Заболевают же главным образом приезжие.
Переносчики эпидемического возвратного тифа - вши Pediculus humanus capitis (головная), P. humanus humanus (платяная). Вошь, насосавшись крови больного, становится способной заразить человека в течение всей своей жизни, так как для вшей боррелии непатогенны, а в гемолимфе насекомого микроорганизмы хорошо размножаются. Трансовариальной передачи боррелий у вшей не существует. Человек заражается, втирая содержащую боррелий гемолимфу вшей (при расчёсывании укуса, раздавливании насекомого) (контаминативное заражение). В окружающей же среде боррелии быстро погибают. При действии температуры 45-48 °С гибель наступает через 30 мин. Эпидемическим возвратным тифом болеют только люди.
Клещевой возвратный тиф - зоонозное трансмиссивное заболевание. Возбудителями являются многие виды боррелий: В. duttonii, В. persica, В. hispanica, В. latyschewii, В. caucasica, распространенные в определенных географических зонах. Эти боррелии сходны с возбудителем эпидемического возвратного тифа по морфологии, резистентности к действию факторов окружающей среды, биологическим свойствам.
Переносчики. Клещевой возвратный тиф является облигатно-трансмиссивным заболеванием. Переносится клещами семейства Argasidae, такими как Ornitodorus papillares (поселковый клещ), Argas persicus (персидский клещ). Клещи являются резервуарными хозяевами спирохет. Резервуаром боррелий различных видов в природных очагах являются также разные виды грызунов. Зараженность клещей сохраняется в течение всей их жизни (около 10 лет). Имеет место и трансовариальная передача возбудителей, которые проникают в яйцевод и яйцеклетки членистоногих. В природных очагах происходит постоянная циркуляция возбудителя от грызунов к клещам и обратно. Животные и паразитирующие на них клещи обычно накапливаются в норах, пещерах, но находят для себя обитание и в различных хозяйственных строениях в населенных пунктах.
Человек заражается при укусах клеща. На месте инокуляции возбудителя образуется папула (первичный аффект).
Население эндемичных по клещевому возвратному тифу районов приобретает определенную степень невосприимчивости к циркулирующим возбудителям - в сыворотке крови у них обнаруживаются антитела к боррелиям, распространенным в этом регионе. Заболевают же главным образом приезжие.
Переносчики эпидемического возвратного тифа - вши Pediculus humanus capitis (головная), P. humanus humanus (платяная). Вошь, насосавшись крови больного, становится способной заразить человека в течение всей своей жизни, так как для вшей боррелии непатогенны, а в гемолимфе насекомого микроорганизмы хорошо размножаются. Трансовариальной передачи боррелий у вшей не существует. Человек заражается, втирая содержащую боррелий гемолимфу вшей (при расчёсывании укуса, раздавливании насекомого) (контаминативное заражение). В окружающей же среде боррелии быстро погибают. При действии температуры 45-48 °С гибель наступает через 30 мин. Эпидемическим возвратным тифом болеют только люди.
Патогенез
Патогенез и клинические проявления клещевых возвратных тифов сходны с эпидемическим. Заболевания чаще возникают в теплое время года с активизацией жизнедеятельности клещей.
Лечение
Для лечения эпидемического возвратного тифа используют антибиотики (пенициллин, левомицетин, хлортетрациклин) и мышьяковистые препараты (новарсенол). При лечении клещевого тифа используются антибиотики тетрациклинового ряда, левомицетин, ампициллин.